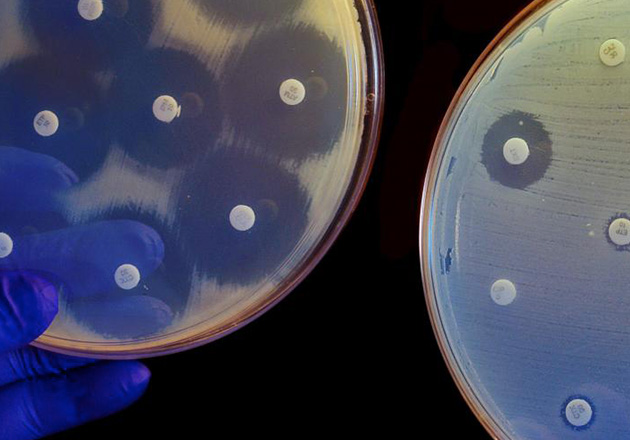

News
Contributions from our Crick community are welcome and can be featured here.
 21 March 2023
21 March 2023
Did you miss any of the talks from the first Imperial@Crick seminar series? If so, a selection of recordings can be viewed on the HEI Seminar Series page of this site.
 15 March 2023
15 March 2023
Calls are now open for Doctoral Clinical Fellows to apply to present a poster, deliver a talk or attend the Crick’s fourth annual Clinical Research Fellows Meeting on Tuesday 20 June 2023. Full details can be found on the Doctoral Clinical Fellows area of this site.
.jpg) 14 February 2023
14 February 2023
Imperial-Crick attachment holder Professor Ed Tate has been appointed to the GSK Chair in Chemical Biology. Full story available on Imperial’s main news website.
 02 February 2023
02 February 2023
The call for applications to the Crick Attachment Programme is now open until 23:59 on Monday 3 April 2023! This is an excellent way for our academics to foster links with the Crick. More information can be found on the College’s Attachment webpages.
 31 January 2023
31 January 2023
Applications for associate interest group membership are now open until Tuesday 21 March 2023. This is an excellent way to bring together scientists working on diverse biological systems. Full information can be found on the College’s Interest Group Seminar webpage.
 30 January 2022
30 January 2022
The Networking Fund call is now open again! Please apply before Monday 3 April 2023 if you wish to apply for up to £3000 funding towards an Imperial-Crick networking event. Full details on the College’s Funding Opportunities webpage.
 26 January 2023
26 January 2023
Interested in being a second supervisor to a core-Crick funded PhD student? The Crick will be running a Zoom webinar about the role and prospective projects on Wednesday 8 February 2023 from 1000 until 1100. To attend, please email the Imperial-Crick Partnership Manager, Dr Corinne Hanlon, for the Zoom link.
 18 January 2023
18 January 2023
Following last year's inaugural meeting, the second Crick Rare Diseases Conference will be on Tuesday 28 February from 0900 to 1700 to mark World Rare Diseases Day 2023. Register on the Crick’s website.
18 January 2023
18 January 2023
The Crick’s 10th Medicine at the Crick event is entitled ‘Escaping the antibiotic apocalypse’ and will be hosted by Dr Eachan Johnson (Crick) on Thursday 2 March 2023 from 1400 until 1815. Register on the Crick’s website.
 18 January 2023
18 January 2023
The UK Chaperone Club will cover a wide range of topics spanning the fundamental basis and regulation of protein folding in the cell, to the relevance of these processes in health and disease. The event will be held on Monday 17 April 2023 from 1000 until 1700. Register on the Crick’s website.
 12 December 2022
12 December 2022
Applications are now open for the Crick’s Programme for Up and Coming Life Sciences Entrepreneurs (PULSE) in conjunction with the BIA (visit BIA website). The deadline to apply is 22 January 2022 and the course will run 20–22 March 2023. Full details available on the PULSE website.
 05 December 2022
05 December 2022
Do you wish to work more closely with our partners at the Crick, UCL or King’s? Do have an idea for an event to increase networking opportunities? If so, there is up to £3000 available to you through the Networking Fund. There are three or four calls per year and the deadline to apply for the current call is 16 December 2022. Contact Dr Corinne Hanlon (c.hanlon@imperial.ac.uk) if you are interested in applying.
 15 October 2022
15 October 2022
Applications are open for the Crick’s Clinical PhD. Apply to the three-year programme before midday on Tuesday 15 November 2022 if you wish to pursue a career in research. Full details on the Crick’s Clinical Doctoral Fellows webpage.
 10 October 2022
10 October 2022
The call for entry to the Crick’s PhD programme is now open. If you wish to embark upon a career in biomedical research, apply before midday on Thursday 10 November 2022. Full details on the Crick’s PhD students webpage.
 03 October 2022
03 October 2022
The Crick is seeking applicants for the role of Clinical Group Leader. The deadline to apply is 23.59 on Thursday 3 November 2022. Full details on the Crick’s Clinical Group Leader webpage.
 26 September 2022
26 September 2022
For those with funding in place, the call for Clinical Postdoctoral Training Fellows is open year-round. The call for fully Crick funded fellowships will open in March 2023. Full details on the Crick's Postdoctoral Clinical Fellows webpage.
 04 August 2022
04 August 2022
The 3rd London Infections and Immunity Symposium will take place at the Crick on Monday 31 October and Tuesday 1 November 2022. This two-day hybrid event will highlight cutting edge research on infectious diseases and immunology taking place across London with keynote lectures from Doreen Cantrell (University of Dundee) and Gordon Brown (Exeter). Full details and registration on the Crick’s website.
 04 August 2022
04 August 2022
Attention biomedical engineers and materials scientists – the 6th Biological Making Workshop will be held on Tuesday 11 October 2022. The event will focus on innovative engineering devices for biomedical research and cover microfluidics and biomaterials, electronics, optics, mechanics, macro and micro manufacturing and features Donald E. Ingber (Wyss Institute for Biologically Inspired Engineering, Harvard). Full details and registration on the Crick’s website.
 24 June 2022
24 June 2022
Crick Attachment holder Dr Marco Di Antonio (Chemistry) has been awarded one of eight 2022 Lister Research Prize Fellowships, which comes with £250,000 in flexible funding. Dr Di Antonio’s group develops chemical tools to assess how DNA changes structurally and chemically during ageing and disease development. Read more on Imperial’s main news website.
 07 June 2022
07 June 2022
Dr Irene Miguel-Aliaga from the MRC London Institute of Medical Sciences will be speaking at this event (Sunday 9 and Monday 10 October) where state-of-the-art developmental biology across the lifecourse will be showcased. The multidisciplinary programme will highlight the latest innovations in live imaging of developing systems, organoid approaches to unravel developmental mechanisms, and the mathematical modelling of morphogenesis and organ homeostasis. Full details and registration on the Crick’s website.
 07 June 2022
07 June 2022
Featuring a talk from the Department of Immunology and Inflammation’s Dr Jessica Strid, this year's Crick Cancer Research Symposium (Monday 3 and Tuesday 4 October) will consider multiple angles of cancer research and provide a forum for lively discussion. Full details and registration on the Crick’s website.
 07 June 2022
07 June 2022
Co-organised by Imperial PI and Crick Group Leader Ben Schumann and the Royal Society of Chemistry, the aim of the meeting is to unify the chemical biology/drug discovery community with applications in biomedicine. For this two-day event (Monday 12 and Tuesday 13 September), the organisers have put together an exceptional lineup of speakers and we hope that you will join us. Full details and registration on the Crick’s website.
 07 February 2022
07 February 2022
The 2022 call for applications to the attachment programme is open from Monday 7 February until 1500 on Monday 4 April 2022. Full details can be found on the Attachment Programme pages of this site. For any further information, please contact the Crick-Imperial Partnership Manager, Dr Corinne Hanlon c.hanlon@imperial.ac.uk.
 04 February 2022
04 February 2022
In her capacity as Chair of the Crick Advisory Group (CAG), Professor Maggie Dallman will be giving a series of talks to various departments and groups over the coming weeks around the opportunities open to our community through the Crick Partnership including the attachment programme. This is open to College staff only. To find out dates, please email the Crick-Imperial Partnership Manager, Dr Corinne Hanlon c.hanlon@imperial.ac.uk. Original photo © Chris Ansell DiffusedLight Photography.
 01 February 2022
01 February 2022
Demis Hassabis, the founder and CEO of DeepMind, gives the first lecture in the Crick's fifth year anniversary event series on 24 February 2022 from 16:00 until 17:10. Visit the Crick website to sign up to attend this virtual event.
 28 January 2022
28 January 2022
Considering applying for an attachment at the Crick? Join us as we hear the experiences of some of UCL's attachment holders (Paola Bonfanti, Jernej Ule, Edina Rosta, and Mariya Moosajee). Full details on our Events page in HEI Seminar Series.
 21 January 2022
21 January 2022
Call now open: Medicine at the Crick, Thursday 17 March 2022. Hosted by the Crick's Prof Dominique Bonnet with lectures from Prof John Dick (Princess Margaret Cancer Centre, University of Toronto), Prof Axel Behrens (CRUK Convergence Science Centre, Institute of Cancer Research & Imperial College London), Prof Simona Parrinello (UCL Cancer Institute) and Prof Jeremy Rich (UPMC Hillman Cancer Centre). Full details and registration on the Crick's website.
 10 January 2022
10 January 2022
Imperial-Crick Physical Sciences Group Leader Dr Louise Walport one of three Imperial researchers to be awarded European Research Council Starting Grants worth collectively more than €4.5 million. Read the full story on Imperial's news website.
 31 December 2021
31 December 2021
Professor Wendy Barclay, Crick satellite holder, Head of Department of Infectious Disease and Chair in Influenza Virology - awarded a CBE for her contributions to the study of viruses and her research during the COVID-19 pandemic. Read the full story on Imperial's news website.
 10 December 2021
10 December 2021
Imperial-Crick Physical Sciences Group Leader Dr Ben Schumann named an EMBO (European Molecular Biology Organisation) Young Investigator. The Young Investigator Programme recognises and supports outstanding life scientists in early stages of their independent careers. Read the full story on Imperial's news website.
 22 November 2021
22 November 2021
Aspiring entrepreneurs and first time CEOs: the call is now open for the PULSE programme (Programme for Up and coming Life Science Entrepreneurs) which will run 14–16 March 2022. Apply on BIA's PULSE website.
 17 November 2021
17 November 2021
The Beddington Development Biology Symposium will run from 7–8 February 2022. To submit an abstract by 16 December 2021, or to register to attend, please visit the Crick’s website.
 12 November 2021
12 November 2021
The Crick’s first ever Rare Diseases Conference will run on 28 February 2022. Register on the Crick’s website.